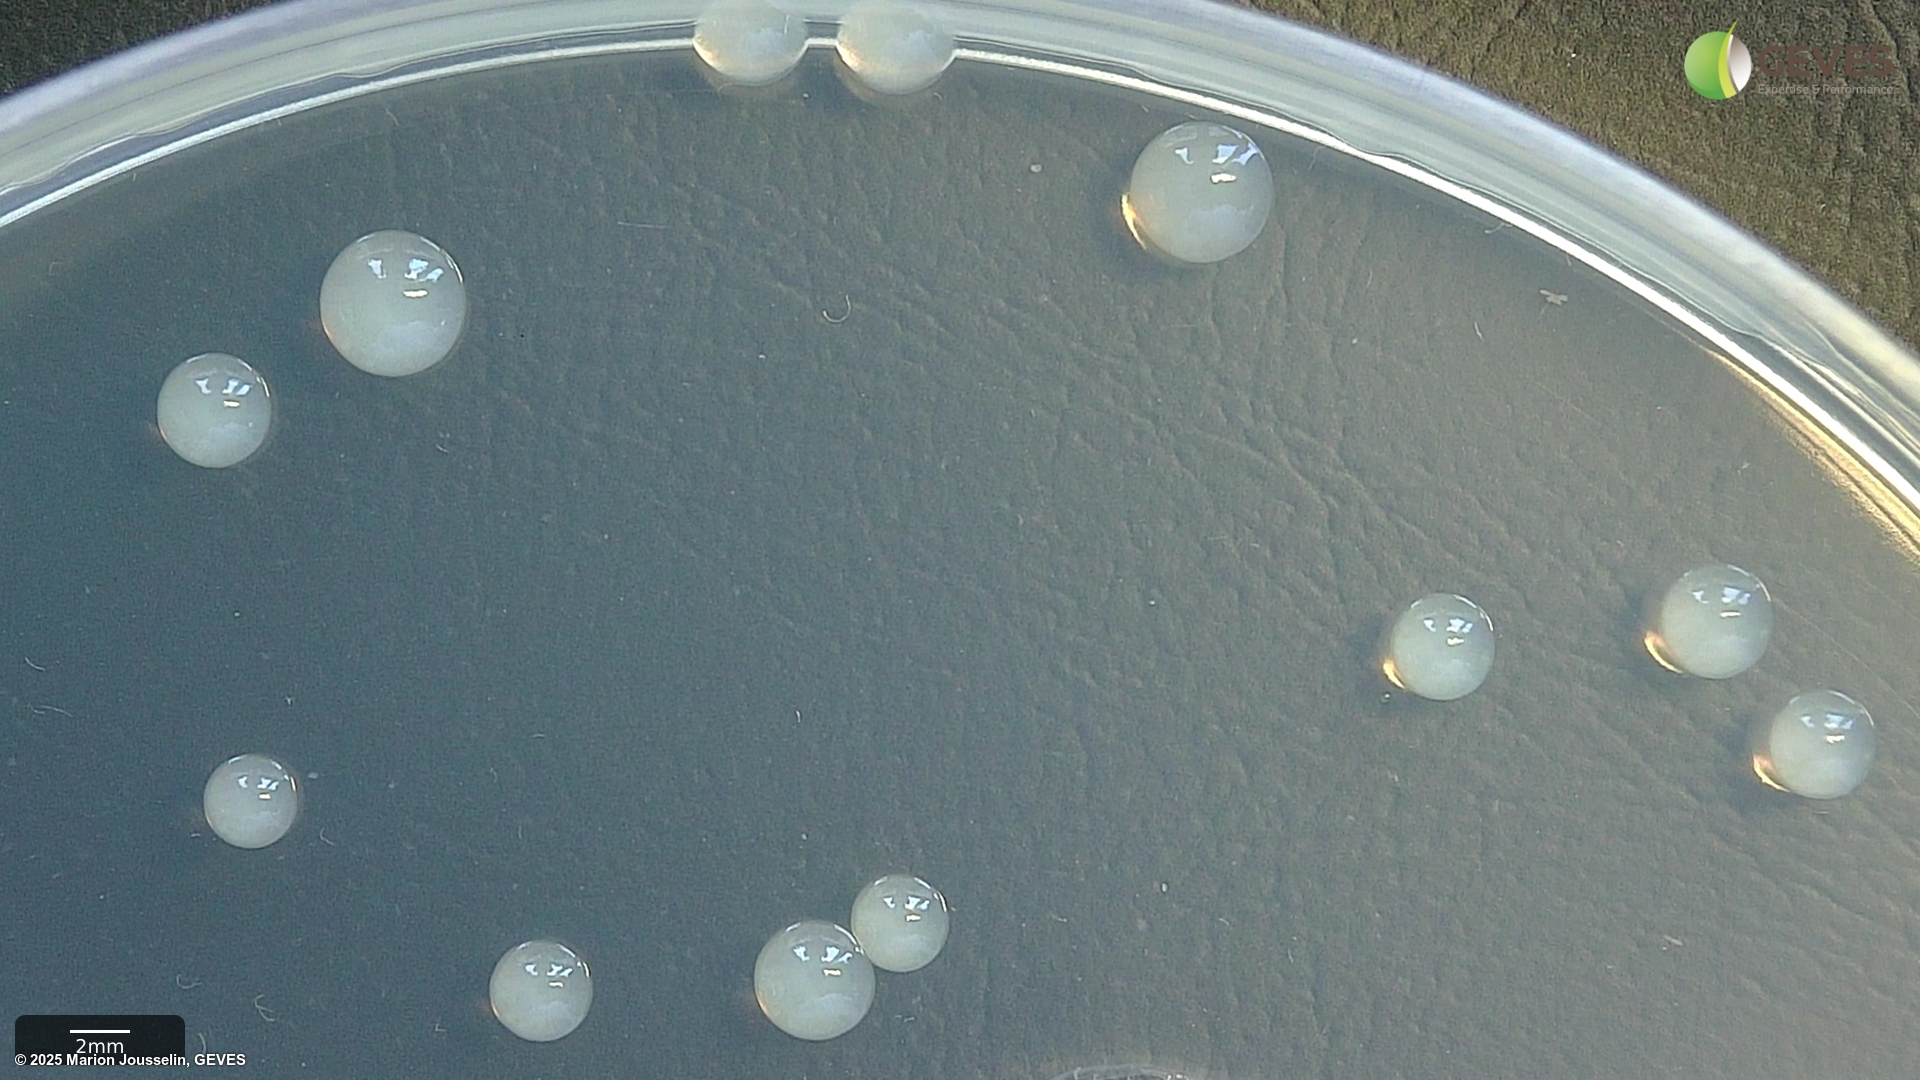
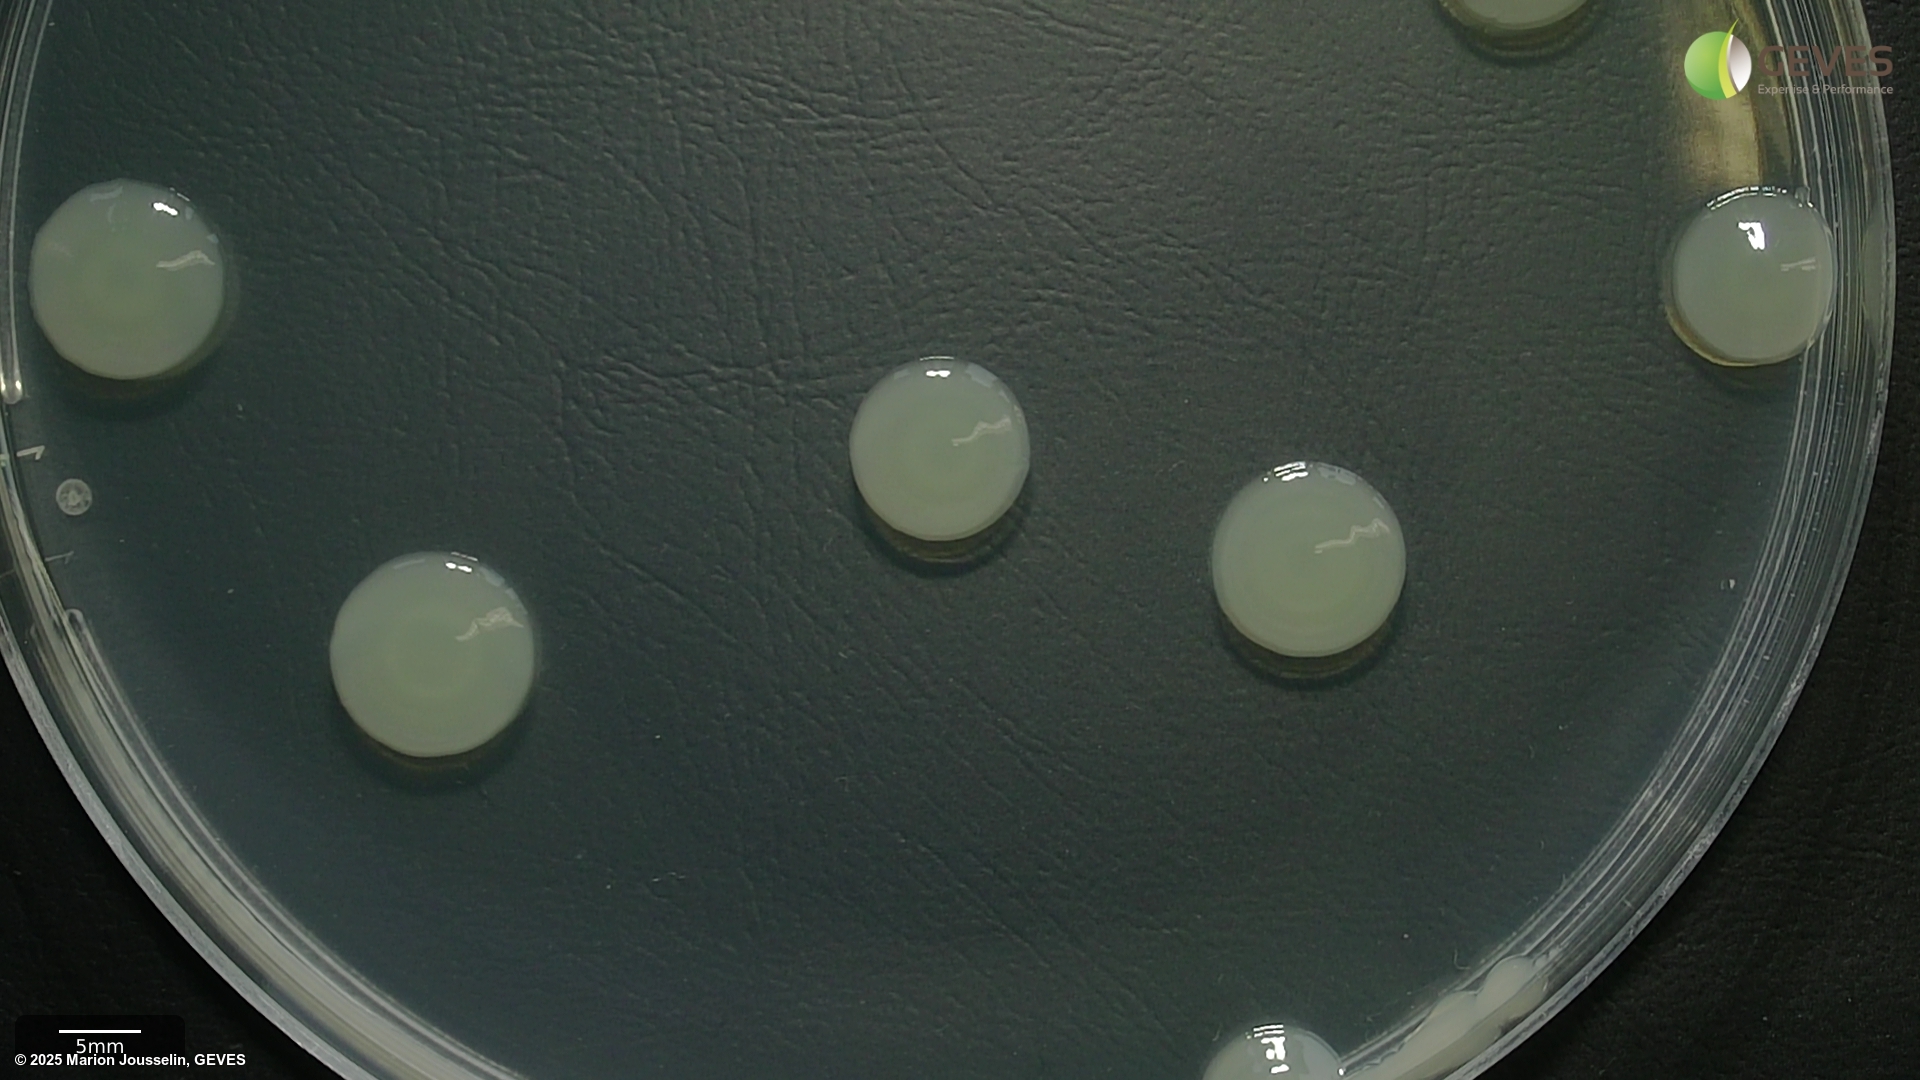

Pathogen
Pseudomonas syringae pv. tabaci
Overview
|
Scientific name
|
Pseudomonas syringae pv. tabaci |
|
Genus
|
Pseudomonas |
|
EPPO code
|
PSDMTA |
|
Common name
|
Wildfire, black fire and angular leaf spot of Tobacco |
|
Synonyms
|
Xanthomonas tabaci |
Description
This description is a ‘stub’ as ISTA has no previous publications on this pathogen. If you would like to contribute and expand this, please feel free to email us at contact@seedhealthtestimagedb.info